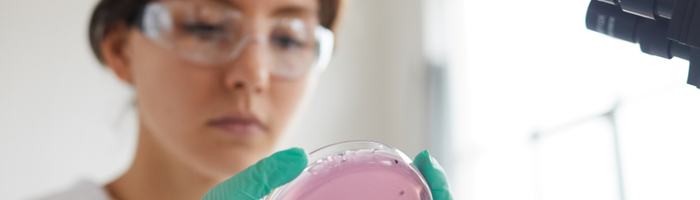

Christiane Meier erzählt, warum Prävention ihre neue Berufung ist, weshalb der Abschied von der Patientinnenarbeit dennoch schmerzte und wieso sie ihren Entscheid keine Sekunde bereut.

Im Interview erzählt Dr. David Crook (Leitender Arzt Radiologie) von seinen Highlights, den Herausforderungen des Fachs, dem Einfluss von KI und davon, warum er das Spital Muri als besonderen Arbeitsplatz schätzt.

Ob sich ein freiwilliger Einkauf in die Pensionskasse lohnt, hängt von den Leistungen der jeweiligen Pensionskasse ab. Mit ein paar wenigen Abklärungen lässt sich der Mehrwert eines Einkaufs in die Vorsorgeeinrichtung beurteilen.

Interview mit Dr. med. Heidi Eckrich über die neue Klinik für Kinder- und Jugendpsychiatrie Graubünden, die 2026 eröffnet wird.

Die eigene Laufbahn aktiv gestalten – in Abstimmung mit dem Privatleben: Im ärztlichen Beruf ist dies ein besonderer Balanceakt. Zwei Ärztinnen berichten über ihre Erfahrungen dazu und zeigen, wie eine Projektumsetzung zur lebensphasenorientierten Laufbahngestaltung dabei helfen kann.

Mit 16 Jahren wusste sie: Die Medizin ist ihre Berufung. Heute ist Dr. Tharshika Thavayogarajah Oberärztin i.V. für Innere Medizin und engagiert sich klinisch-wissenschaftlich im Bereich der Hämatologie. Ein Gespräch über Herausforderungen, Forschung, Mentoring – und den Mut, als Frau in der Medizin neue Wege zu gehen.

Basierend auf über 13 Jahren Erfahrung in der ärztlichen Personalvermittlung hat Radiolutions fünf Merkmale identifiziert, die besonders attraktive Arbeitgeber im Klinikbereich auszeichnen – auch im Schweizer Gesundheitswesen.

Ein Gastbeitrag von Enzian Health, wie Schweizer Arztpraxen verbringen viele Ärzt:innen wertvolle Zeit mit starken, leitenden MPAs und klarer Führungsrolle Strukturen schaffen Strukturen, die Ärzt:innen den Rücken freihalten.

Ingrid Burkhardt ist beruflich grösstenteils im Ausland tätig – für mehrere Projekte in Entwicklungsländern. Im Ausland hat sie mit ihrem Partner auch drei Kinder bekommen. Wie lässt sich all dies vereinbaren?

Der Karriereweg von Ärztinnen und Ärzten in der Schweiz ist klar strukturiert – vom Studium bis zur Führungsposition. Wir geben einen Überblick.

Valeria Scheiwiller (eh. swimsa Präsidentin und Assistenzärztin Psychiatrie) spricht im Interview über ihren spannenden Weg, ihre Ungeduld und Impact.

Dipl. Ärztin Nevriye Tuna erzählt im Interview von ihrem Werdegang und weshalb sie die Tätigkeit als Hausärztin liebt.

Im Interview erzählt uns Dr. Fabian Kraxner mehr über Resilienz, Selbstfürsorge und wie kleine Routinen im Alltag eine grosse Wirkung haben können.

Raphael Minder, Experte in der Ärztevermittlung, unterstützt mit Medimeo Praxen und Spitäler auf der Suche nach Mediziner:innen aus der Schweiz und dem deutschsprachigen Raum. Im Interview spricht er darüber, wie sich Arbeitgeber abheben können und wie er den Markt einschätzt.

Die Karriere als Ärztin oder Arzt in der Schweiz bietet viele Chancen, bringt aber auch Herausforderungen mit sich. Raphael Minder, Experte in der Ärztevermittlung, gibt wertvolle Tipps für Bewerber:innen.

Der Podcast “Mensch im Mittelpunkt” der WHM gibt wertvolle Einblicke und praxisnahe Tipps zur Facharzt-Weiterbildung in der ambulanten Medizin.

Viele Schweizer Spitäler und Praxen kämpfen mit Ärztemangel. Welche Strategien helfen, Fachkräfte gezielt zu gewinnen? Erfahre, wie digitale Sichtbarkeit, Employer Branding und optimierte Bewerbungsprozesse den Unterschied machen.

Podcasts bieten Ärztinnen und Ärzten eine flexible Möglichkeit, sich weiterzubilden und inspirieren zu lassen. Entdecke spannende Formate mit Expertenwissen, Karrieretipps und Einblicken in den medizinischen Alltag.

Hausärztinnen und Hausärzte sind essenziell für die medizinische Grundversorgung in der Schweiz. Erfahre, wie du den Beruf ergreifen kannst, welche Karrierewege offenstehen und welche Chancen die Hausarztmedizin bietet.

Wie viel verdienen Assistenz- und Oberärzt:innen in der Schweiz? Hier erfährst du aktuelle Gehaltszahlen, Lohnbänder und Zulagen – sowie die wichtigsten Faktoren, die das Einkommen beeinflussen.

Das Medizinstudium in der Schweiz gehört zu den anspruchsvollsten und angesehensten Ausbildungen. Erfahre, welche Voraussetzungen du erfüllen musst, wie das Studium abläuft und welche Karrierechancen dich erwarten.

Im Interview berichtet Simon Gründler von spannenden Einblicken in die Spitzenforschung und der skandinavischen Work-Life-Balance.

Christian Storm leitet das Nachtarztteam der Klinik Zugersee. Im Interview spricht er über die Herausforderungen der Nachtschicht, akute Notfälle und seine Motivation für diesen anspruchsvollen Beruf.

Die Rekrutierung von Ärztinnen und Ärzten in der Schweiz ist eine Herausforderung. Erfahre, welche Jobplattformen die besten Ergebnisse liefern und auf welche Kennzahlen du bei der Auswahl achten solltest.

PD Dr. med. Ksenija Slankamenac, Ph.D. leitet die Forschung am Institut für Notfallmedizin am USZ. Im Interview spricht sie über ihre Leidenschaft für Innovation, ihren Werdegang und die Bedeutung wissenschaftlicher Arbeit in der Medizin.

Willi und Afreed starteten Swissmedtalk, um ärztliche Karrierewege transparenter zu machen. Im Interview erzählen sie, wie aus ihrer Idee ein erfolgreiches Format wurde und wie sie Studium, Arbeit und Medienprojekte verbinden.

Innerbetriebliche Konflikte sind im Spitalalltag kaum vermeidbar. Erfahre, wie ärztlicher Führungsnachwuchs mit Konflikten umgehen kann, um das Betriebsklima zu verbessern und die eigene Resilienz zu stärken.

Effektives Teaching ist essenziell für die Ausbildung von Assistenzärztinnen und -ärzten. Erfahre, wie kurze, gezielte Lehrmomente im Klinikalltag genutzt werden können, um Wissen praxisnah zu vermitteln.

Die neuen modularen Vorsorgepläne von Medpension bieten mehr Flexibilität und individuelle Gestaltungsmöglichkeiten. Erfahre, wie Praxen ihre Attraktivität als Arbeitgeber steigern und Mitarbeitende optimal absichern können.

Dagmar Keller ist Chefärztin, Sportlerin und Mentorin. Im Interview spricht sie über ihren Karriereweg, ihre Faszination für neue Herausforderungen und gibt wertvolle Tipps für angehende Führungskräfte in der Medizin.

Dr. Sara Straub wusste schon als Kind, dass sie Kinderärztin werden möchte. Im Interview erzählt sie, wie sie ihren Traum verwirklicht hat und was sie an der Arbeit mit ihren kleinen Patient:innen besonders schätzt.

Mariana Marti ist Fachärztin und Gründerin von ILERA, einer Plattform zur Unterstützung und Vernetzung von Ärztinnen. Im Interview erzählt sie, wie sie dazu kam und wie sie andere auf ihrem Karriereweg begleitet.

Ali Sigaroudi kombiniert als Facharzt mehrere Tätigkeiten in Spital, Notfallpraxen und Startups. Im Interview erzählt er, warum er sich für diesen vielseitigen Arbeitsstil entschieden hat und welche Vorteile er darin sieht.

Gaby Bieri leitet die Gesundheitszentren für das Alter und erklärt, warum echte ärztliche Kunst nicht nur heilt, sondern Lebensqualität schenkt. Im Interview spricht sie über ganzheitliche Medizin und den besonderen Wert ihrer Arbeit.

Ärztinnen und Ärzte bei Ärzte ohne Grenzen leisten medizinische Hilfe, wo sie am dringendsten benötigt wird. Erfahre, welche Möglichkeiten es gibt, wie Einsätze ablaufen und welche Voraussetzungen du mitbringen solltest.

Wer eine eigene Praxis in der Schweiz eröffnen möchte, muss zahlreiche rechtliche Vorgaben beachten. Erfahre, welche Bewilligungen nötig sind, welche Berufspflichten gelten und was für eine erfolgreiche Niederlassung wichtig ist.

Die strukturierte Weiterbildung ist für Ärztinnen und Ärzte in Weiterbildung verpflichtend, wird aber oft nicht ausreichend umgesetzt. Erfahre, was genau darunter fällt und warum sie ein wichtiger Teil der Ausbildung ist.

Svenja Ravioli zog für ein Jahr nach London, um als Notfallärztin neue Perspektiven zu gewinnen. Im Interview spricht sie über ihre Erfahrungen im britischen Gesundheitssystem und die Unterschiede zur Schweiz.

Praxisgemeinschaften werden immer beliebter, doch eine erfolgreiche Zusammenarbeit erfordert klare Absprachen und eine gemeinsame Strategie. Im Artikel erfährst du, worauf es bei einer Praxispartnerschaft ankommt und welche Stolpersteine du vermeiden solltest.

Die Rekrutierung von Ärzt:innen stellt viele Arbeitgeber vor Herausforderungen. Wie du mit klarer Kommunikation, gezielten Massnahmen und strategischer Planung die passenden Fachkräfte findest, erfährst du hier

Die Wahl der richtigen Pensionskasse ist für Arztpraxen eine zentrale Entscheidung. Doch welche Kriterien sind entscheidend und worauf sollte besonders geachtet werden? Ein Überblick über die wichtigsten Aspekte und Kennzahlen.

Wie modulare Vorsorgepläne Abhilfe bei der Altersvorsorge für Teilzeitbeschäftigte schaffen.

Ob Anerkennung deines Diploms durch die MEBEKO, Arbeitsbewilligungen oder die richtige Versicherung – hier findest du alle wichtigen Infos für einen erfolgreichen Karrierestart als Arzt oder Ärztin in der Schweiz.

Was ist zu beachten bei einer Gründung einer medizinischen Praxis in Bezug auf berufliche Vorsorge und Versicherungen.

Der Start ins Medizinstudium in der Schweiz kann überwältigend sein – neue Umgebung, viel Stoff und zahlreiche Herausforderungen. Mit den richtigen Tipps und etwas Vorbereitung kannst du die ersten Monate erfolgreich meistern und dich schnell einleben. Hier findest du acht wertvolle Ratschläge für einen gelungenen Studienbeginn.

Im Februar hatte ich die Chance, im Unispital Basel auf der Anästhesie anzufangen. Lest hier über meine Erlebnisse im Land der Träume.

Du studierst Medizin und interessierst dich für die Forschung? Dann könnte ein MD-PhD Doktoratsprogramm genau das Richtige für dich sein.
Damit du dich Dr. med. nennen kannst, musst du eine Dissertation verfassen und promovieren. Wir zeigen dir, wie du deine Dissertation erfolgreich planst.

Krisen machen auch vor Ärzt:innen keinen Halt. Das Unterstützungsnetzwerk ReMed der FMH fängt Ärzt:innen in Krisensituation auf und unterstützt auf Augenhöhe von Arzt zu Arzt.

Erfahre in diesem Beitrag mehr über das Angebot von mediservice und wie du davon profitieren kannst.

Die Facharztausbildung in der Schweiz umfasst 45 Spezialisierungen, die vielfältige Karrieremöglichkeiten bieten. Wir geben dir einen Überblick über die nicht-chirurgischen, teil-chirurgischen und chirurgischen Disziplinen sowie deren Dauer und Karrierechancen.

Mit Coach my Career können junge Ärzt:innen vom reichen Erfahrungsschatz ihrer erfahrenen Kolleg:innen profitieren.

Hier findest Du eine Übersicht über die Medianlöhne als Assistenzärzt:in in der Schweiz. Die Unterschiede sind beträchtlich.

Wir zeigen dir, wie du dein Wahlstudienjahr erfolgreich planst und geben dir ein paar Tipps mit auf den Weg.

Einige Mediziner:innen entscheiden sich nach dem Studium für alternative Karrierewege jenseits der klassischen Tätigkeit im Spital oder in der Praxis. Ob Klinikmanagement, Pharmaindustrie oder Forschung – die Möglichkeiten sind vielfältig. Wir zeigen dir, welche spannenden beruflichen Optionen Dir mit einem Medizinstudium offenstehen.

Hast du ein ausländisches Arztdiplom und möchtest in der Schweiz arbeiten? Erfahre, welche Schritte du für die Anerkennung deines Diploms durch die MEBEKO unternehmen musst – abhängig von der Herkunft deines Abschlusses und den spezifischen Anforderungen der Schweiz.

Mit myfellowship.com will Mohy Taha die Suche nach internationalen Lern- und Forschungsaufenthalten vereinfachen. In dieser Ausgabe von Medicus am Puls erfährst du wie.

Wie kann man die Administration in der Medizin vereinfachen? Zwei Assistenzärzte lancieren eine innovative Plattform zum Teilen von Berichtevorlagen.

Wir geben Dir wichtige Tipps für Dein erstes Vorstellungsgespräch als Assistenzärzt*in.

Zu Jahresbeginn erhalten Versicherte von ihrer Pensionskasse ihren persönlichen Versicherungsausweis. Doch was genau verbirgt sich hinter den Fachbegriffen und Zahlen, die darin enthalten sind?

Wir zeigen dir, wie du erfolgreich ein Bewerbungsdossier für deine erste Stelle nach dem Staatsexamen verfasst.